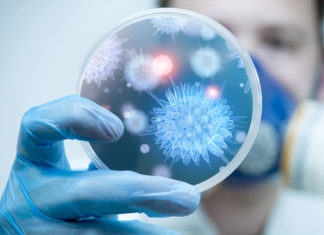
Cáncer: ¿estamos cerca de una cura?

¿Puedes aprender mientras duermes? Sí, te explicamos
Se sabe que el sueño es crucial para el aprendizaje y la formación de la memoria. Lo que es más, los científicos incluso han...
La hora del almuerzo: cómo no se deben tomar los alimentos
¿Qué usted hace por regla general, cuando se sienta a desayunar, almorzar o cenar? ¿Mira su serie de TV favorita, revisa su correspondencia con...
¿Cuánta sangre hay en el cuerpo humano?
La sangre representa aproximadamente del 7 al 8 por ciento del peso corporal de una persona. Siga leyendo para averiguar el volumen promedio de...
¿Puedes vivir con un gato si tienes alergias?
Las personas con alergias a los gatos reaccionan a sustancias específicas que los gatos producen, como la saliva, los copos de la piel llamados...
Bacterias resistentes al antibiótico de último recurso, omitidas en las pruebas...
Los microbiólogos de Emory han detectado "heterorresistencia" a la colistina, un antibiótico de último recurso, en Klebsiella pneumoniae, una bacteria altamente resistente que causa...
No es solo sexo: por qué las personas tienen aventuras y...
Desde políticos hasta actores y artistas, las historias de individuos de alto perfil que son descubiertos como "tramposos" con sus parejas suelen ser noticia...
Las píldoras anticonceptivas aumentan el riesgo de accidente cerebrovascular isquémico
Los anticonceptivos orales aumentan el riesgo de accidente cerebrovascular isquémico, pero este riesgo es muy pequeño entre las mujeres que no tienen otros factores...
Cáncer: ¿estamos cerca de una cura?
El cáncer es la principal causa de muerte en todo el mundo. Desde hace años, los investigadores han llevado a cabo estudios meticulosos centrados...
Diabetes: un estudio propone cinco tipos, no dos
Los adultos con diabetes podrían beneficiarse de un mejor tratamiento si la condición se categoriza en cinco tipos, en lugar de solo dos. Esta...
La ansiedad puede ayudarte a sobrevivir a un ataque al corazón
Si vives con ansiedad, probablemente estés familiarizado con el círculo vicioso de estar ansioso por estar ansioso. Una forma útil de romper el ciclo...
¿Cuáles son los efectos de la meningitis?
La meningitis es la inflamación de las meninges, que son las membranas que protegen el cerebro y la médula espinal. Esta inflamación generalmente ocurre...
Alzheimer revertida en ratones por médicos de Cleveland Clinic
En lo que podría ser un avance en la lucha contra la enfermedad de Alzheimer, los investigadores de Cleveland Clinic han revertido los efectos...